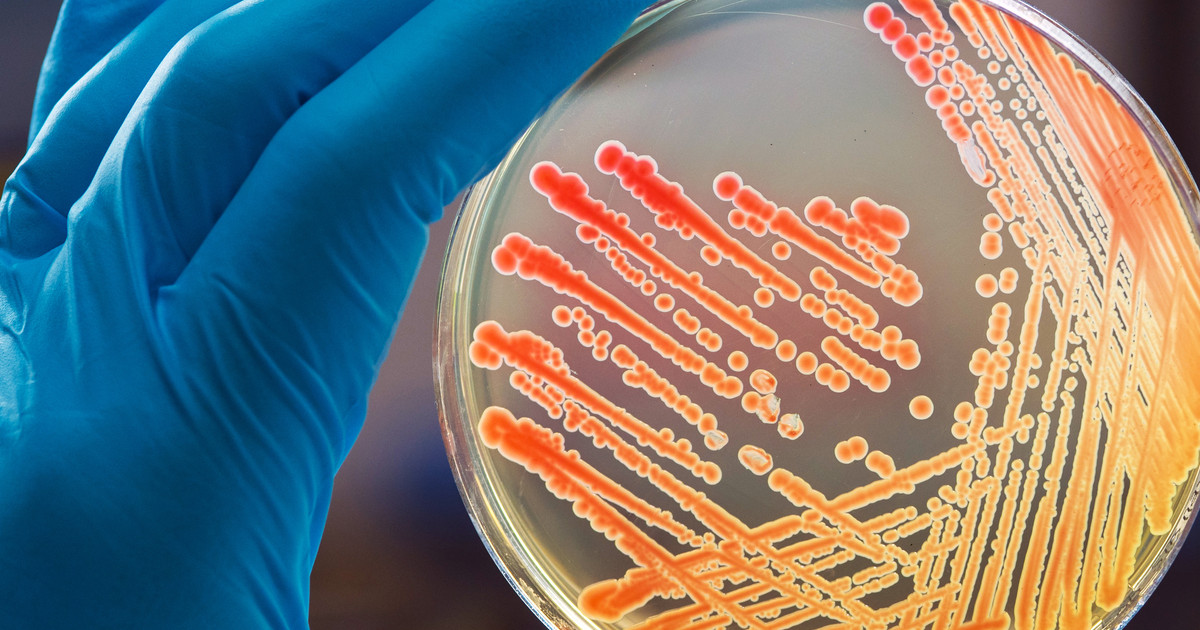

Guide To Azithromycin
Azithromycin is a powerful antibiotic that treats severe bacterial infections! Patients will most often take this medication as an oral pill. However, it is also available intravenously, when required! Both children and adults can take this antibiotic. It is particularly great at treating ear infections in children! Patients will take this medication for three to five days for most infections. Severe infections need up to ten days!
Azithromycin is among the common antibiotics for bacterial skin infections! Oral antibiotics like this one are incredibly effective. It is no wonder that they are prescribed for many conditions. This particular one is even considered a safe antibiotic for kids! Antibiotic resistance is possible, but proper use minimizes this risk. Of course, patients should only get azithromycin once they understand it!
How It Works
Azithromycin is a macrolide antibiotic! It is a synthetic derivative of erythromycin, the first of this class, which was isolated in the 1950s. The type of bacteria it was isolated from is found in the soil! This antibiotic gets rid of bacteria very effectively. It does it by attaching to a subunit on the ribosomes! This subunit is called the P site of the 505 unit. It is a very specific part of the bacteria! The medication stops bacteria from spreading and forming proteins. Antibiotics in this class have the best impact on gram-positive cocci and intracellular pathogens!
Reveal the uses and benefits of this antibiotic next.
Uses And Benefits

Azithromycin is most commonly used for throat, sinus, and ear infections. It also treats skin and respiratory infections! Examples of conditions it is often prescribed for are pneumonia, bronchitis, and sinusitis. It is also very helpful in pneumonia treatment when patients are allergic to penicillin! This antibiotic also treats cellulitis and impetigo. It will make a significant positive impact on folliculitis and pelvic inflammatory disease too. 'Off-label' uses for this medication include bacterial endocarditis and acne! Some doctors will prescribe it for cat-scratch disease as well.
Continue reading to learn about the potential side effects linked to this antibiotic next.
Side Effects

This antibiotic causes some side effects, just like other medications! Patients most commonly experience nausea and diarrhea. Swelling and a fever also occur with this antibiotic. An individual's skin will become red or crusty in some cases too! These side effects are minor. They will go away on their own! However, patients must mention them to their doctor. They will help patients keep track and detect any issues earlier!
Rare side effects include appetite loss, muscle pain, and blood in the urine. Others are increased coughing and congestion. Headaches and earaches due to this medication are also rare! Even rarer side effects of this medication include indigestion and jaundice. Patients will also encounter dry mouth, taste changes, and white patches in their mouth. The room will also feel like it is spinning in rare cases! Issues swallowing, vision and hearing changes, and mood shifts are serious side effects. Patients must inform their doctor of all serious and rare side effects they experience!
Get the full details on the medication precautions next!
Precautions To Remember

Patients need to review their medical history with their doctor before taking this medication. Doctors will use this information to ensure this antibiotic is safe! Items of note include a history of liver issues and jaundice. A history of kidney disease matters too! Doctors will also review their patient's heart health. This includes an irregular heartbeat or heart failure. They need to know about a history of any heart issues!
Patients will also be more sensitive to the sun when they take this antibiotic. Thus, they have to avoid sun exposure! When they are in the sun, they need to use sunscreen all the time. Wearing protective clothing is also vital!
Discover the medication interactions associated with this antibiotic next.
Medication Interactions

Azithromycin has over three hundred medication interactions linked to it. Out of these, there are more than sixty major drug interactions! One of the major interactions is with blood thinners such as warfarin. It will also interact with some heart medications and other antibiotics! They have to exercise caution with antacids. When their antacids contain magnesium or calcium, they need to take them at least two hours before or after azithromycin.
Patients need to make a list of all their current medications. This list must have all prescriptions and over-the-counter medications. Patients cannot forget to include all herbal supplements and vitamins on this list as well. They must give this to their doctor, who will check for potential interactions! The pharmacist will double-check this list as well.
